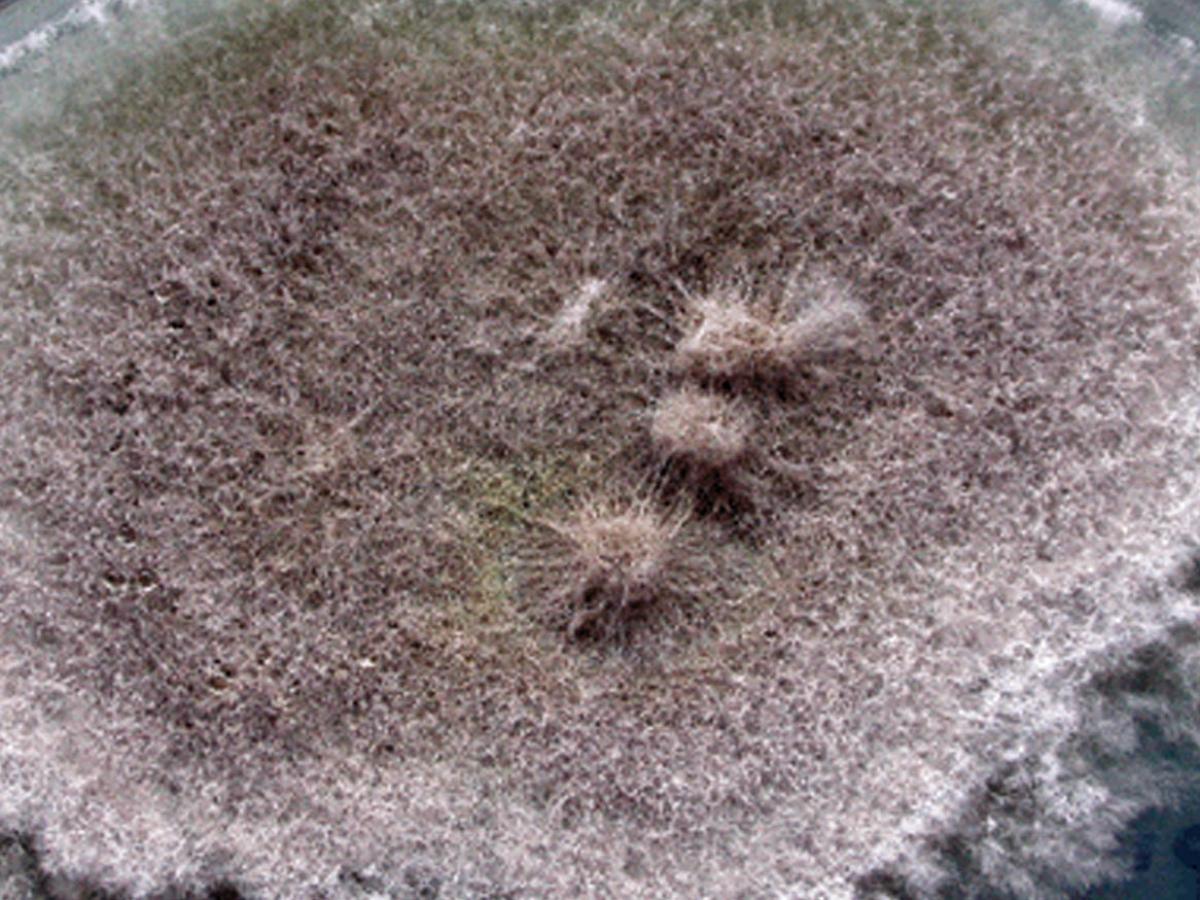
Culture

Status message
Correct! Excellent, you have really done well. Please find additional information below.
Unknown 11 = Scedosporium apiospermum
Culture: Colonies are fast growing, greyish-white, suede-like to downy with a greyish-black reverse.
Microscopy: Numerous single-celled, pale-brown, broadly clavate to ovoid conidia, rounded above with truncate bases are observed. Conidia are borne singly or in small groups on elongate, simple or branched conidiophores or laterally on hyphae.

Comment: Scedosporium apiospermum is a common soil fungus with a worldwide distribution. Environmental isolations have been made from sewage sludge, polluted streams, and manure of poultry and cattle. Clinical manifestations include the following:
Non-invasive colonization of the external ear and pulmonary colonization in patients with poorly draining bronchi or paranasal sinuses and "fungus ball" formation in pre-formed cavities are similar to those seen in Aspergillus.
Invasive infections in normal patients are usually caused by traumatic implantation. Mycetoma, where the fungus exists in tissue as resistant microcolonies or grains is the most common infection in the normal patient. This is followed by penetrating joint injuries, especially to the knee, resulting in arthritis and osteomyelitis. Other manifestations include mycotic keratitis and non-mycetoma like cutaneous and subcutaneous infections.
Invasive infections have also been reported in patients receiving treatment with corticosteroids and immunosuppressive therapy for organ transplantation, leukaemia, lymphoma, systemic lupus erythematous or Crohn's disease. Infections include invasive sinusitis, pneumonia, arthritis with osteomyelitis, cutaneous and subcutaneous granulomata, meningitis, brain abscesses, endophthalmitis, and disseminated systemic disease.
About Scedosporium Back to virtual assessment